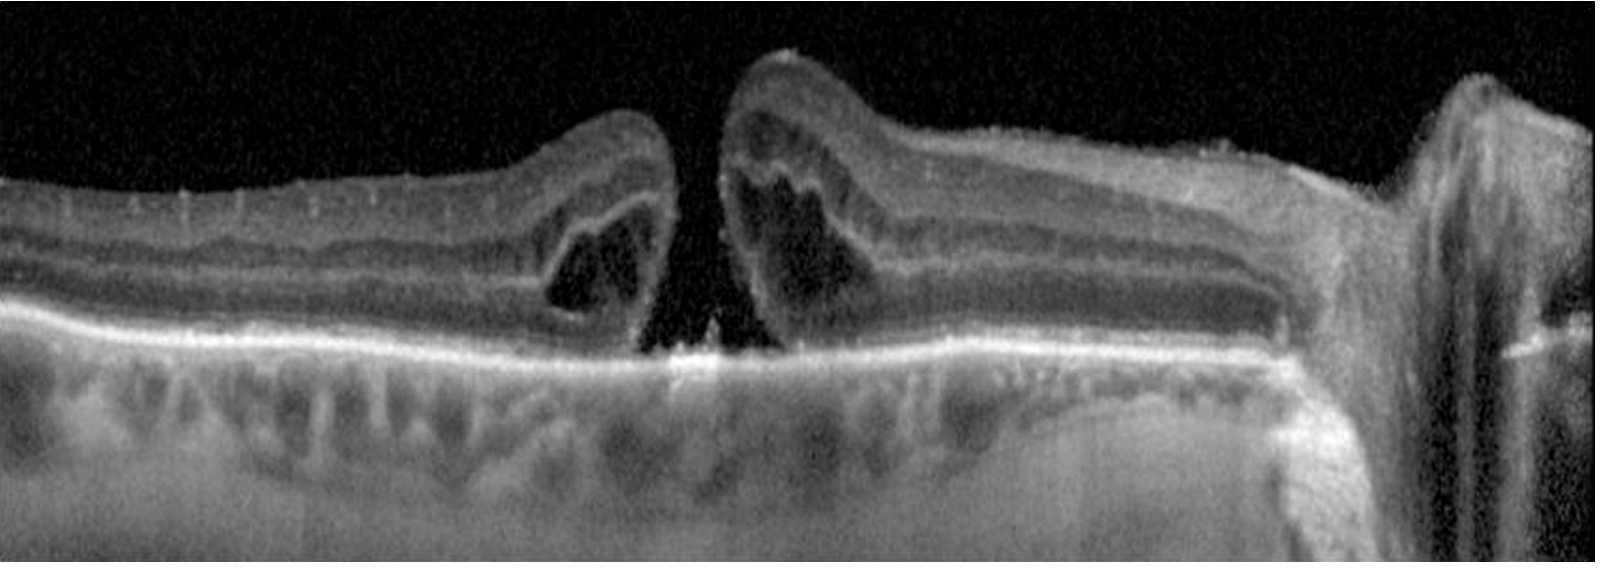

Macular hole
Reading File
Finding Sources
Searching PubMed
"macular hole"[MeSH Terms] AND treatment
Reading File
Reading File
Finding Sources
Reading File
Reading File
Reading File
Reading File
Reading File
Loading Image
Loading Image
A macular hole is a full-thickness defect at the fovea (center of the macula) that causes central vision loss and distortion.
Key points
- Most often affects women age 60 to 70
- Usually idiopathic and related to vitreomacular traction (VMT) during posterior vitreous detachment
- Can also occur with high myopia or blunt trauma
- Bilateral involvement risk is clinically relevant (about 10% to 30% reported depending on cohort/setting)
Typical symptoms
- Blurred central vision in one eye
- Metamorphopsia (straight lines look wavy)
- Central scotoma
- Early/impending stages may be minimally symptomatic
Diagnosis
- OCT is the key test for confirmation and staging
- Fundus exam may show a round red foveal lesion with a cuff/halo
- Watzke-Allen slit-beam test may show a perceived break in the beam over a true full-thickness hole
- Differentiate from:
- Lamellar macular hole
- Macular pseudohole from epiretinal membrane
- Chronic CME-related cystic changes
- Solar retinopathy
Staging
Classic Gass staging:
- Stage 1: impending hole
- Stage 2: small full-thickness hole
- Stage 3: full-thickness hole, no complete PVD
- Stage 4: full-thickness hole with complete PVD
Modern OCT-based classification also uses:
- Hole size (small, medium, large)
- Presence/absence of VMT
- Etiology (primary vs secondary)
Management
- Stage 1: often observation (many resolve spontaneously)
- Symptomatic full-thickness holes (especially stage 2+): pars plana vitrectomy with ILM peel and gas tamponade is standard of care
- Better outcomes when treated earlier, especially within about 6 months
- Post-op face-down positioning may be used (shorter protocols common with modern techniques)
- Ocriplasmin may be considered in selected early small VMT-related cases, but use is limited by variable efficacy and side effects
- Cataract progression after vitrectomy in phakic patients is very common
Prognosis
- Anatomical closure rates are high after surgery
- Vision often improves over months
- Smaller holes and shorter duration generally have better visual outcomes
- Some full-thickness holes can close spontaneously
Example images
Fundus stages of macular hole:


OCT appearance of macular hole:

Recent evidence check:
- A quick PubMed search limited to the last 2 years for systematic reviews/meta-analyses on “macular hole treatment” returned no hits, so no immediate high-level contradiction signal was identified from that narrow filter.
Sources:
- Kanski's Clinical Ophthalmology: A Systematic Approach, 10th ed, p. 626-629
- The Wills Eye Manual, p. 866-870
If you want, I can give you a one-page patient-friendly version or a retina-specialist-level surgical decision flowchart.
Need for 15 marks
Macular Hole (15-mark answer)
Definition
A macular hole is a full-thickness defect in the neurosensory retina at the fovea, causing central visual impairment.
Epidemiology
- Common in older adults, especially 60 to 70 years
- Female preponderance
- Usually unilateral at presentation, but fellow-eye risk exists (about 10% or more over time)
Etiology and Pathogenesis
- Idiopathic (most common)
Related to age-related vitreous changes and anomalous posterior vitreous detachment. - Vitreomacular traction (VMT)
Persistent vitreofoveal adhesion causes anteroposterior and tangential traction, leading to foveal dehiscence. - Secondary causes
- High myopia
- Blunt ocular trauma
- Less commonly cystoid macular edema-associated tractional changes
Classification
A. Gass Clinical Staging
- Stage 1: Impending hole (yellow spot/ring at fovea)
- Stage 2: Small full-thickness macular hole
- Stage 3: Full-thickness hole with cuff of subretinal fluid, without complete PVD
- Stage 4: Full-thickness hole with complete PVD
B. OCT-Based Classification (current practical approach)
- Based on:
- Hole size (small, medium, large)
- Presence/absence of vitreomacular traction
- Etiology (primary/secondary)
Clinical Features
Symptoms
- Painless diminution of central vision
- Metamorphopsia
- Central scotoma
- Reading difficulty
- Early stages may be minimally symptomatic
Signs
- Round red foveal lesion
- Gray cuff/halo (subretinal fluid) around full-thickness hole
- Possible operculum
- Loss of normal foveal contour in VMT stages
Investigations
- Optical Coherence Tomography (OCT)
Gold standard for diagnosis, staging, and follow-up. - Amsler grid
Detects central distortion. - Watzke-Allen test
Thinning/break in slit beam perception suggests true full-thickness hole. - Fundus biomicroscopy
For morphology and associated vitreoretinal interface abnormalities. - FA/FAF (selected cases)
Usually not required when OCT is diagnostic.
Differential Diagnosis
- Lamellar macular hole
- Macular pseudohole (epiretinal membrane)
- Chronic CME with central cystic change
- Solar retinopathy
- Other foveal lesions mimicking a hole
Management
1. Observation
- Stage 1 holes are often observed because spontaneous resolution can occur.
- Small spontaneous closure can also occur in some full-thickness holes.
2. Pharmacologic vitreolysis
- Ocriplasmin in selected VMT/small early holes
- Limited use due to variable efficacy and adverse effects
3. Surgical treatment (standard for symptomatic full-thickness holes)
- Pars plana vitrectomy + ILM peeling + gas tamponade
- Relieve traction, promote hole closure
- Better outcomes when operated early (preferably within ~6 months of onset)
- Postoperative prone positioning may be advised for selected duration
Prognosis
- High anatomical closure rates after surgery
- Visual recovery occurs over months
- Better visual outcomes with:
- Smaller hole size
- Shorter symptom duration
- Earlier surgery
- Cataract progression in phakic eyes after vitrectomy is common
Complications
- Persistent/recurrent hole
- Cataract progression
- Retinal detachment (uncommon but important)
- Other vitrectomy-related complications
Follow-up
- Monitor with serial OCT
- Counsel regarding symptoms of retinal detachment
- Periodic fellow-eye assessment due to bilateral risk
Short conclusion
Macular hole is an important treatable cause of central visual loss in older adults. OCT is central to diagnosis and staging, and modern vitrectomy with ILM peel and gas tamponade provides high closure rates and useful visual recovery, especially when intervention is early.
CMV RETINITIS for 15 marks
CMV Retinitis (15-mark answer)
Definition
CMV retinitis is a necrotizing viral retinitis caused by cytomegalovirus, seen mainly in severely immunocompromised patients, classically advanced HIV/AIDS, but also transplant recipients and patients on strong immunosuppression.
Etiology and Risk Factors
- Causative agent: Human cytomegalovirus (HHV-5)
- Major risk groups:
- HIV with very low CD4 count (especially <50 cells/µL)
- Solid organ/hematopoietic stem cell transplant
- Prolonged corticosteroids, chemotherapy, biologics, immunosuppressants
- Hematologic malignancy, congenital immunodeficiency
Pathogenesis
- CMV reactivation occurs in profound immunosuppression
- Hematogenous spread to retina causes full-thickness retinal necrosis
- Associated occlusive vasculitis and hemorrhage
- Lesions spread centrifugally along vessels if untreated
- Healed lesions become atrophic scars, predisposing to retinal breaks and detachment
Clinical Features
Symptoms
- Floaters
- Blurred vision
- Scotoma
- Photopsia
- Painless progressive visual loss
(Early peripheral disease may be asymptomatic)
Signs (Fundus)
- Yellow-white granular retinal necrosis with retinal hemorrhages
classic “pizza pie” or “cottage cheese with ketchup” appearance - Perivascular whitening/sheathing
- Minimal anterior chamber/vitreous inflammation compared with lesion extent
- May be unilateral initially, with risk of fellow-eye involvement if untreated
Clinical Patterns
- Fulminant/edematous form
Dense hemorrhagic necrotizing lesions, often posterior pole - Indolent/granular form
Peripheral granular lesions with slower progression - Frosted branch angiitis-like vasculitis (less common)
Diagnosis
Primarily clinical in a high-risk patient:
- Dilated fundus examination (cornerstone)
- Wide-field fundus photography for documentation
- OCT for macular involvement/complications
- Aqueous/vitreous PCR (CMV DNA) when diagnosis is uncertain or atypical
- HIV testing/CD4 count and systemic immunologic workup where relevant
Differential Diagnosis
- Acute retinal necrosis (HSV/VZV)
- Progressive outer retinal necrosis
- Toxoplasma retinochoroiditis
- Syphilitic retinitis
- Candida endophthalmitis
- Intraocular lymphoma
Treatment
1) Anti-CMV induction therapy
- Valganciclovir (oral) commonly used if sight-threatening disease is absent
- IV ganciclovir for severe/bilateral/systemic disease
- Foscarnet (alternative or resistant/intolerant cases)
- Cidofovir less favored due to toxicity profile
2) Local therapy for sight-threatening lesions
(near macula/optic disc or rapidly progressive disease)
- Intravitreal ganciclovir or foscarnet, often combined with systemic therapy for rapid local control
3) Maintenance and immune restoration
- Continue maintenance therapy until immune recovery (in HIV, sustained CD4 improvement on ART)
- Start/optimize ART in HIV patients (timing individualized)
- Coordinate with physician/infectious disease specialist
Monitoring and Follow-up
- Frequent retinal exams during induction (often weekly initially)
- Watch for progression at lesion borders, new lesions, fellow-eye disease
- Hematologic and renal monitoring for drug toxicity
- Long-term follow-up for structural sequelae
Complications
- Rhegmatogenous retinal detachment (major cause of severe visual loss)
- Optic atrophy
- Macular scarring/edema
- Immune recovery uveitis after ART initiation
- Drug adverse effects:
- Ganciclovir/valganciclovir: neutropenia, thrombocytopenia
- Foscarnet: nephrotoxicity, electrolyte disturbances
- Cidofovir: nephrotoxicity, uveitis/hypotony
Prognosis
- Visual outcome depends on:
- Lesion location (macula/optic nerve involvement worse)
- Speed of diagnosis and treatment
- Degree of immune reconstitution
- Prognosis has improved markedly in the ART era, but relapse and late complications remain significant.
Prevention
- Early HIV diagnosis and effective ART
- In transplant and high-risk patients: virologic monitoring and pre-emptive CMV strategies
- Patient education to report new floaters, field defects, or blurred vision immediately
Short conclusion
CMV retinitis is an ophthalmic emergency in immunocompromised patients. Prompt recognition of characteristic necrotizing hemorrhagic retinitis, early anti-CMV induction (systemic ± intravitreal), and restoration of immune function are the keys to preventing irreversible blindness and reducing recurrence.
Pneumatic retinopexy
Pneumatic Retinopexy (15-mark answer)
Definition
Pneumatic retinopexy is a minimally invasive procedure for selected rhegmatogenous retinal detachments (RRD), in which an intravitreal expansile gas bubble is injected to close retinal breaks, followed by retinopexy (laser or cryotherapy) to create permanent chorioretinal adhesion.
Principle
- Gas bubble rises and tamponades superior retinal break(s)
- Subretinal fluid is gradually absorbed by RPE pump
- Laser photocoagulation or cryopexy seals the break permanently
- Strict postoperative head positioning is essential to keep bubble apposed to break
Indications (ideal case selection)
- Primary RRD with:
- Single break or a small group of breaks within 1 clock hour
- Break(s) in superior retina (approximately 8 to 4 o'clock)
- Clear enough media for retinal visualization
- Patient able to maintain required head posture and follow-up
- Phakic eyes often have better single-procedure success than pseudophakic eyes
Contraindications / Poor candidates
- Inferior retinal breaks
- Large/multiple widely separated tears
- Significant proliferative vitreoretinopathy (PVR C or more)
- Advanced giant retinal tear/dialysis (except selected expert settings)
- Marked vitreous hemorrhage or media opacity
- Inability to posture, travel constraints, or poor compliance
- Need for air travel or nitrous oxide anesthesia while gas persists
Preoperative Evaluation
- Detailed dilated fundus exam with scleral indentation (both eyes)
- Identify all breaks and assess PVR
- Macula-on vs macula-off status documentation
- Baseline visual acuity and IOP
- Counsel regarding positioning, follow-up urgency, and red-flag symptoms
Procedure (outline)
- Topical/local anesthesia and asepsis
- Paracentesis may be done in selected cases to control IOP
- Intravitreal injection of expansile gas (commonly SF6 or C3F8; nonexpansile concentration as per protocol)
- Immediate positioning so bubble occludes causative break
- Retinopexy:
- Laser photocoagulation once retina apposes (often within 24 to 48 h), or
- Cryotherapy at/around break depending on visualization and surgeon preference
- Serial re-examination to confirm reattachment and detect missed/new breaks
Postoperative Instructions
- Strict head posture for several days as advised
- No air travel, high altitude exposure, or nitrous oxide anesthesia until gas resolves
- Report pain, sudden vision drop, new floaters/flashes immediately
- Frequent early follow-up (often day 1, then within days to week)
Advantages
- Office-based, less invasive
- Short procedure time, lower cost
- Faster recovery and less conjunctival scarring
- Less refractive change and less cataract progression compared with vitrectomy in many cases
- Can preserve future options (scleral buckle/PPV if needed)
Limitations
- Highly dependent on case selection and compliance with posture
- Lower single-procedure success than PPV in some case mixes
- Missed or new retinal breaks can cause failure
- May require secondary surgery
Complications
- Persistent/recurrent retinal detachment
- New or missed retinal breaks
- Elevated IOP, pupillary block (rare)
- Gas migration (rare)
- Vitreous hemorrhage
- Choroidal detachment (uncommon)
- Epiretinal membrane, PVR progression
- Endophthalmitis (very rare)
- Subretinal gas (rare, technique-related)
Outcomes
- Good anatomical and visual outcomes in properly selected superior-break RRD
- Best results in:
- Phakic eyes
- Single superior tear
- Minimal PVR
- Good adherence to positioning
- Failure usually managed with repeat pneumatic, scleral buckle, or pars plana vitrectomy
Comparison with Other Procedures
- Vs scleral buckle: less invasive, faster recovery, but narrower indications
- Vs PPV: office-based and lens-sparing advantages, but PPV may have higher primary success in complex/pseudophakic/multiple-break detachments
Short conclusion
Pneumatic retinopexy is an effective, minimally invasive treatment for carefully selected superior-break rhegmatogenous retinal detachments. Success depends on meticulous preoperative break identification, correct gas/posture strategy, and close follow-up to detect early failure or additional breaks.
Intravitreal implants
Intravitreal Implants (15-mark answer)
Definition
Intravitreal implants are drug-delivery devices placed inside the vitreous cavity to provide sustained release of medication for posterior segment diseases, reducing the need for frequent injections.
Rationale
- Blood-retinal barrier limits systemic drug penetration
- Repeated bolus injections have fluctuating drug levels
- Implants provide longer, steadier intraocular concentration
- Useful in chronic, recurrent retinal disorders
Classification
1) By biodegradability
- Biodegradable implants
- Break down over time
- Usually steroid based
- Non-biodegradable implants
- Long-acting reservoir systems
- May require surgical placement/removal in some designs
2) By drug class
- Corticosteroid implants
- Antiviral implants (historical/selected contexts)
- Anti-VEGF sustained-delivery systems (newer)
- Experimental: immunomodulatory/gene-based long-duration platforms
Commonly used intravitreal implants
A. Dexamethasone biodegradable implant (Ozurdex, 0.7 mg)
- Indications:
- Diabetic macular edema (selected cases)
- Macular edema due to retinal vein occlusion
- Noninfectious posterior uveitis
- Duration: approximately 3 to 6 months (variable)
- Delivered via office-based injector
B. Fluocinolone acetonide implants
- Iluvien/Yutiq type micro-implant (injectable, very low dose release)
- Long duration (up to about 3 years in approved settings)
- Used in chronic DME (selected patients) and noninfectious uveitis (product/region dependent)
- Retisert type surgical implant
- Sutured implant for chronic noninfectious posterior uveitis
- High local steroid effect but higher ocular side-effect burden
C. Ganciclovir implant (historical)
- Used in CMV retinitis before modern systemic/ART era strategies
- Largely replaced by current systemic + intravitreal pharmacotherapy protocols
D. Ranibizumab port delivery system (PDS) (where available)
- Refillable sustained-release anti-VEGF reservoir for neovascular AMD
- Reduces injection frequency but requires surgical implantation and monitoring
Indications (exam-friendly)
- Chronic/refractory diabetic macular edema
- Macular edema due to RVO
- Noninfectious intermediate/posterior/panuveitis
- Selected neovascular AMD (sustained anti-VEGF systems)
- Rarely/older indication: CMV retinitis (ganciclovir implant)
Contraindications
- Active ocular/periocular infection
- Active infectious uveitis (for steroid implants)
- Advanced uncontrolled glaucoma
- Significant media opacity precluding follow-up (relative)
- Hypersensitivity to implant components
Technique (general outline)
- Informed consent and indication confirmation
- Aseptic intravitreal procedure in OT/procedure room
- Pars plana entry with preloaded injector (for injectable implants)
- Check optic nerve perfusion/IOP and implant position
- Post-procedure monitoring and scheduled follow-up
Advantages
- Sustained drug delivery and reduced treatment burden
- Better adherence in chronic disease
- Lower systemic exposure than systemic therapy
- Useful when frequent visits/injections are difficult
Disadvantages
- Procedure-related risks
- Steroid-response glaucoma and cataract
- Cost and availability limitations
- Some systems require surgery/refill
Complications
- Common/important
- Raised IOP, steroid-induced glaucoma
- Cataract progression (especially with steroid implants)
- Procedure-related
- Endophthalmitis
- Vitreous hemorrhage
- Retinal tear/detachment (rare)
- Hypotony (rare)
- Implant-specific
- Implant migration (risk in aphakia or posterior capsular defects for dexamethasone implant)
- Device erosion/exposure or conjunctival complications (surgical implants)
- Need for re-implantation/refill as effect wanes
Follow-up
- Monitor visual acuity, OCT, IOP, lens status
- Watch for infection or inflammation
- Re-treatment planning based on anatomical and functional response
- In steroid implants, regular glaucoma surveillance is mandatory
Comparison with repeated intravitreal injections
- Implants: fewer procedures, steadier drug levels, but device-related risks and steroid effects
- Monthly/PRN injections: flexible and titratable, but high visit burden and adherence issues
Short conclusion
Intravitreal implants are an important sustained-delivery strategy for retinal disease, especially DME, RVO-related macular edema, and noninfectious posterior uveitis. They reduce injection burden but require careful patient selection and close follow-up for IOP rise, cataract, and procedure-related complications.
ONH evaluation
!
An error occurred (ValidationException) when calling the ConverseStream operation: The model returned the following errors: messages.12.content.1.tool_result.content.0.image.source.base64: image exceeds 5 MB maximum: 6876820 bytes > 5242880 bytes
We encountered an error while processing your request. Please try again or reach out to us for help.
This is a shared conversation. Sign in to Orris to start your own chat.